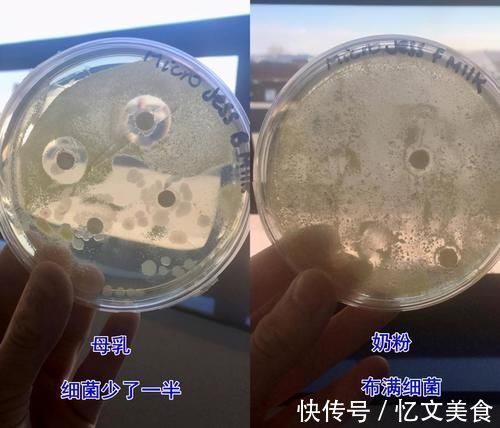
宝妈|母乳到底有多“神奇”?一个实验为你揭晓答案,你可别小瞧了它

文丨C妈学堂
相信要是提起母乳大家都是非常的了解,并且也相信母乳中所含有的营养物质,可以对于宝宝的身体产生非常大的作用。
但是母乳除了提供营养物质之外,到底还有什么样的作用呢?
大家有没有思考过,为什么很多的专家都提倡,宝妈在生完孩子后6个月内进行母乳喂养呢?
这其实也有很多方面的原因,并不是我们所想象的那样简单。

文章插图
关于这个问题的答案,有一部分比较专业的宝妈就开始进行探讨,而且还进行了实验,最后也获得了答案。
然而,大部分宝妈在给孩子进行母乳喂养之前,也是听从了别人的建议,而没有进行任何正规的实验。
而就是因为这个试验,让我能明白了母乳的强大功能,相信你也可以从这些图片中,了解到母乳对于孩子的影响
文章插图
母乳到底有多“神奇”?一个实验为你揭晓答案
之前在英国有一个宝妈,就因为自己生了孩子之后,想要去测试为什么大家都提倡母乳?
所以做了这样一个实验:在一开始的时候,她选择了母乳和配方奶粉留下来的一些物质,将它放到培养皿中,之后还在里面加入了细菌。
【 宝妈|母乳到底有多“神奇”?一个实验为你揭晓答案,你可别小瞧了它】最后通过显微镜的观察,她发现在这之中,母乳杀菌,以及配方奶粉杀菌之间存在很大的不同。
我们甚至可以通过图片非常完整地看到,母乳的杀菌能力非常强,而且相比于配方奶粉可能强过一半。
这也就利用实验证明了:母乳本身所具有的杀菌能力,是配方奶粉所不能比的。
当时这个实验做完之后,通过数据的公开大部分人了解到了母乳所具有的能力,并且坚持给孩子进行了母乳喂养。

文章插图
相信如果我们曾经了解过这个实验之后,也会对此感到十分震惊。
仅仅是一个母乳的分泌,真的有这么大的作用吗?
在大家的想法之中,母乳只是一种营养品,其实母乳会根据宝宝身体的状态进行一定的调节,它也算得上是一个“比较智能的系统”。
最重要的是在不同阶段,它所提供的营养物质是存在很大的不同,所以这也是专家建议大家进行母乳喂养的理由。
当然,除了我们上面所说的几点好处之外,我们也应该了解一下母乳喂养到底有多少好处。

文章插图
母乳喂养到底还有哪些好处呢?
生理健康
母乳喂养可以让宝宝的身体更为健康,为什么这样说呢?
因为从身边接受母乳喂养的孩子观察,可以知道宝宝们都不容易生病,而且身体出现其他问题的可能性也更低,总之就是比较健康。
因为在母乳中会存在一些物质,它们可以去吞噬细菌,从而达到防御细菌保护宝宝身体的作用。
除此之外,其实母乳也会适应孩子本身的肠胃。毕竟刚出生的宝宝肠胃都比较娇嫩,很容易出现问题。
但是母乳也会根据宝宝的身体进行一定的调节,而调节肠胃也是其中的一种“功能”,而且宝宝在吮吸母乳的过程中,对宝宝的大脑发育也会有很好的促进作用。

文章插图
情感心理
不知道大家生完孩子之后,有没有及时的去拥抱自己的孩子,我们也会发现当孩子在哭闹的时候,接触到妈妈的身体,他们就会瞬间的安静下来。
有人说这是母子连心所产生的一种效应,实际上就是因为妈妈和宝宝肌肤接触,可以给孩子一种安全感。
当妈妈在对孩子进行母乳喂养的时候,这种接触就会更加频繁,而宝宝在这样的情况下心理自然也会更有安全感。
所以,我们也会发现母乳喂养的宝宝通常更依赖妈妈,这其实就是因为在这个过程中,亲密的肌肤接触,让孩子感受到了妈妈爱。
等到之后,分离的时候,反抗的情绪就会更为明显,但是父母和孩子所建立的这种亲密链接,确实是无法消除的,对于亲子关系的建立也比较有帮助。

文章插图
对宝妈也有好处
母乳喂养不仅对孩子有好处,对于妈妈的好处也是非常明显的,特别是生完孩子之后,宝妈的身体很虚弱,有一部分宝妈还不愿意给孩子进行母乳喂养。
- 宝妈|那个生完孩子没多久,就变成“老太太”的80后宝妈,后来咋样了
- 妈妈|喝“母乳”和喝“奶粉”的孩子,长大后有哪些区别3个区别明显
- 宝妈|三个月的宝宝,为何“偏爱”竖抱?抱对了的宝宝更聪明
- 医生|让宝妈提心吊胆的“上环”,过程到底是怎么样的?可能会有点尴尬
- 宝宝|8岁男孩依然在吃母乳,断奶几次都失败告终,对孩子会有影响吗
- 口臭|孩子被嘲笑“嘴臭”,遭同学孤立,医生取出的东西宝妈也说臭
- 老师|“请倒数第一名的家长发言”,宝妈的一番发言,让老师羞愧
- 乳汁|从小喝“母乳”和不喝“母乳”的孩子,长大后差别太大了
- 预产期|孕期不能剪头发,否则胎宝会“男变女”?宝妈:我想剃光头
- 产检|产检时,医生可能会告知你这些暗示语,听不懂的宝妈很容易吃亏
